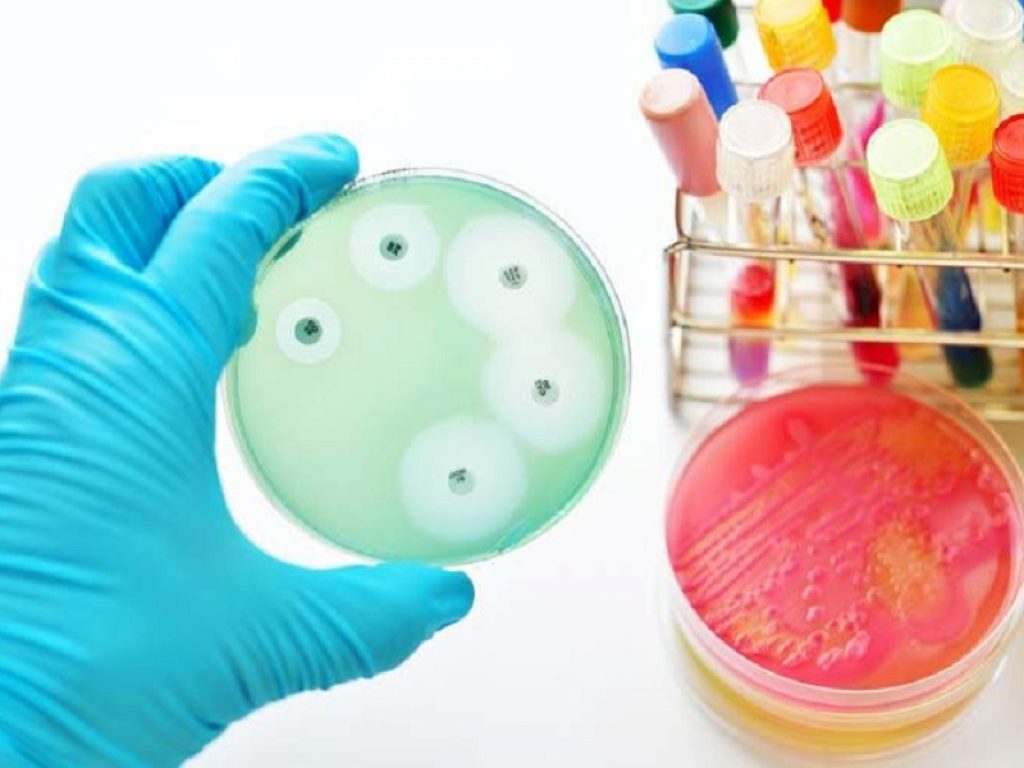
malattia meningococcica

Da uno studio emerge un costante aumento della diffusione della malattia meningococcica in Italia tra il 2011 e il 2017
Non solo emergenza COVID-19. In Italia, i dati della diffusione della malattia meningococcica raccontano di una patologia in aumento e non solo pediatrica, come spesso erroneamente si pensa. Lo studio “Invasive meningococcal disease in Italy: from analysis of national data to an evidence-based vaccination strategy” pubblicato nel 2020 sul Journal of Preventive Medicine and Hygiene ha descritto e reinterpretato i dati epidemiologici della malattia invasiva da meningococco del nostro Paese per gli anni compresi tra il 2011 e il 2017, da cui emerge un costante aumento della diffusione della malattia meningococcica per diversi motivi.
Innanzitutto, a causa della coesistenza di diversi sierogruppi portatori dell’infezione: stando allo studio, i sierogruppi ACWY, considerati insieme, causano la maggior parte dei casi di malattia meningococcica registrati in Italia dal 2013, con una tendenza all’espansione di sierogruppi prima poco rappresentati quali il sierogruppo Y e W. Inoltre, si rileva una prevalenza in pressoché tutte le fasce d’età e un numero alto e in aumento di casi nei gruppi di popolazione di età maggiore. Ecco allora che diventa fondamentale comprendere non solo gli aspetti clinici di questa malattia, ma anche l’impatto economico, etico, e sociale che genera sul comparto ospedaliero, sulla filiera della salute e sul sistema sociale in senso allargato, in una fase segnata dalla pandemia.
Dall’epidemiologia all’Health Technology Assessment
Da questa necessaria visione allargata e sistemica nasce l’Health Technology Assessment sull’estensione della vaccinazione antimeningococcica a coorti aggiuntive: si tratta di un documento redatto da un gruppo multidisciplinare e inter-accademico di esperti delle Università di Firenze, Università di Genova, Università di Roma Tor Vergata che vede il contributo di Chiara Azzari, Professoressa associata di Pediatria Università di Firenze, e del Comitato Nazionale Contro la Meningite. È stato pubblicato in italiano sul numero speciale del Journal of Preventive Medicine and Hygiene di maggio 2021 e presentato in via preliminare da Paolo Bonanni, Professore ordinario di Igiene all’Università di Firenze, in occasione del primo Meningo Summit di Sanofi Pasteur, divisione Vaccini di Sanofi, che ha fornito il supporto non condizionante al progetto.
Si tratta di una valutazione multidimensionale e multidisciplinare che analizza le implicazioni medico-cliniche, sociali, organizzative, economiche, etiche e legali connesse a un ampliamento delle coorti vaccinali con l’obiettivo di contribuire all’individuazione di politiche sanitarie sicure, efficaci, incentrate sui pazienti e mirate a conseguire la presa di decisioni il più possibile informate. Un quadro complessivo che nasce anche da bisogni emergenti legati a una pandemia che diventa sindemia, termine relativamente nuovo che sta ad indicare un insieme di patologie pandemiche non solo sanitarie, ma anche sociali, economiche, psicologiche, di fruizione della cultura e delle relazioni umane, dei modelli di vita. Una rete di interazioni tra elementi biologici e sociali, che alterano e modificano continuamente gli stati e le condizioni di salute.
“Questo Health Technology Assessment, frutto di un prezioso lavoro inter-accademico, risulta un documento di assoluta contemporaneità perché affronta per la prima volta il tema della prevenzione della malattia meningococcica in un quadro complessivo. In questo tempo ancora fragile segnato da una pandemia diventata sindemia è fondamentale prendere in considerazione gli elementi epidemiologici e al contempo gli aspetti sociali, economici, culturali che una patologia può determinare sul sistema sanitario nazionale. Oggi avere una visione sistemica è essenziale per cogliere la complessità dell’impatto sulla salute, anche alla luce dell’emergenza pandemica che stiamo vivendo”, afferma Mario Merlo, General Manager Sanofi Pasteur.
Le evidenze dell’impatto
Nel documento è stata valutata l’epidemiologia, il burden della malattia invasiva da meningococco e delle sequele in diverse fasce di età e per sierogruppo, i costi con l’impatto medio lifetime della malattia meningococcica, mettendo a confronto le attuali strategie vaccinali e raccomandazioni presenti in Italia con una nuova politica vaccinale che prevede l’inserimento di due coorti aggiuntive utili a ridurre i picchi di malattia in alcune fasce di età. Da un punto di vista economico, la valutazione ha evidenziato poi come l’impatto della malattia invasiva meningococcica risulti associato principalmente alle sequele, sia in termini di costi diretti che indiretti e, focalizzando l’attenzione sui benefici economici derivanti dall’ampliamento delle coorti, il vantaggio sia nella prospettiva del Sistema Sanitario Nazionale che della Società. La vaccinazione determina, infatti, non solo una riduzione di casi di malattia, ma anche un beneficio economico e sociale associato ai costi evitati per la cura della malattia e la gestione delle sequele a medio e lungo termine.
L’analisi ha evidenziato, infine come la vaccinazione di coorti aggiuntive con un vaccino coniugato quadrivalente ACWY come quello di Sanofi Pasteur potrebbe tradursi in un beneficio incrementale in termini di riduzione di eventi e di spesa paragonabile a quello già ottenuto con l’attuale strategia di vaccinazione verso la non vaccinazione.